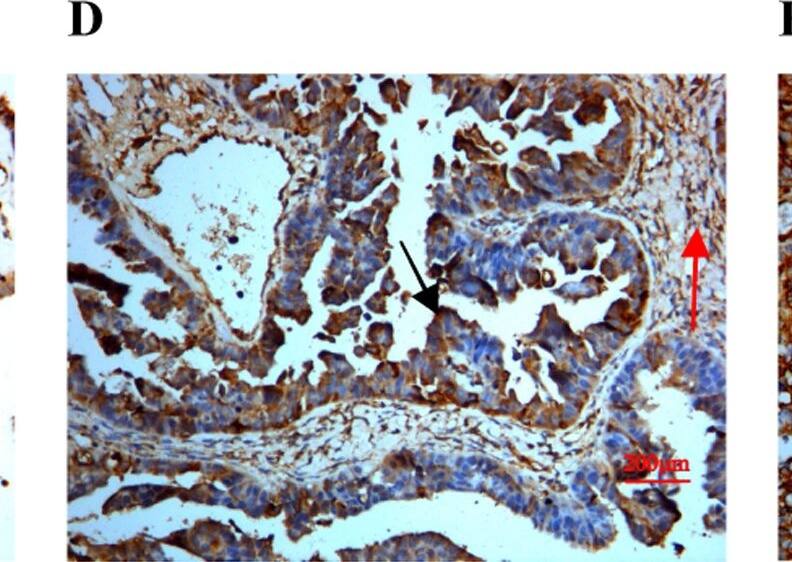
Detection of Human SPARC by Immunocytochemistry/ Immunofluorescence

Human SPARC Antibody
R&D Systems, part of Bio-Techne | Catalog # AF941


Key Product Details
Validated by
Species Reactivity
Validated:
Cited:
Applications
Validated:
Cited:
Label
Antibody Source
Product Specifications
Immunogen
Ala18-Ile303
Accession # P09486
Specificity
Clonality
Host
Isotype
Scientific Data Images for Human SPARC Antibody
Detection of SPARC in MG-63 cells by Flow Cytometry
MG-63 cells were stained with Goat Anti-Human SPARC Antigen Affinity-purified Polyclonal Antibody (Catalog # AF941, filled histogram) or isotype control antibody (Catalog # AB-108-C, open histogram) followed by Allophycocyanin-conjugated Anti-Goat IgG Secondary Antibody (Catalog # F0108). To facilitate intracellular staining, cells were fixed with Flow Cytometry Fixation Buffer (Catalog # FC004) and permeabilized with Flow Cytometry Permeabilization/Wash Buffer I (Catalog # FC005). View our protocol for Staining Intracellular Molecules.Detection of Human SPARC by Western Blot.
Western blot shows lysates of MG-63 human osteosarcoma cell line. PVDF membrane was probed with 2 µg/mL of Goat Anti-Human SPARC Antigen Affinity-purified Polyclonal Antibody (Catalog # AF941) followed by HRP-conjugated Anti-Goat IgG Secondary Antibody (HAF019). A specific band was detected for SPARC at approximately 43 kDa (as indicated). This experiment was conducted under reducing conditions and using Immunoblot Buffer Group 1.SPARC/Osteonectin in Human Ovary.
SPARC/Osteonectin was detected in immersion fixed paraffin-embedded sections of human ovary using Goat Anti-Human SPARC/Osteonectin Antigen Affinity-purified Polyclonal Antibody (Catalog # AF941) at 3 µg/mL overnight at 4 °C. Tissue was stained using the Anti-Goat HRP-DAB Cell & Tissue Staining Kit (brown; CTS008) and counterstained with hematoxylin (blue). View our protocol for Chromogenic IHC Staining of Paraffin-embedded Tissue Sections.Applications for Human SPARC Antibody
CyTOF-ready
ELISA
This antibody functions as an ELISA detection antibody when paired with Mouse Anti-Human SPARC Monoclonal Antibody (Catalog # MAB941).
This product is intended for assay development on various assay platforms requiring antibody pairs. We recommend the Human SPARC DuoSet ELISA Kit (Catalog # DY941-05) for convenient development of a sandwich ELISA or the Human SPARC Quantikine ELISA Kit (Catalog # DSP00) for a complete optimized ELISA.
Immunohistochemistry
Sample: Immersion fixed paraffin-embedded sections of human ovary, normal human liver, and human liver cancer tissues
Intracellular Staining by Flow Cytometry
Sample: MG‑63 human osteosarcoma cell line fixed with paraformaldehyde and permeabilized with saponin
Simple Western
Sample: MG‑63 human osteosarcoma cell line
Western Blot
Sample: MG‑63 human osteosarcoma cell line
Reviewed Applications
Read 4 reviews rated 4.8 using AF941 in the following applications:
Formulation, Preparation, and Storage
Purification
Reconstitution
Formulation
*Small pack size (-SP) is supplied either lyophilized or as a 0.2 µm filtered solution in PBS.
Shipping
Stability & Storage
- 12 months from date of receipt, -20 to -70 °C as supplied.
- 1 month, 2 to 8 °C under sterile conditions after reconstitution.
- 6 months, -20 to -70 °C under sterile conditions after reconstitution.
Background: SPARC
SPARC, an acronym for “secreted protein, acidic and rich in cysteine”, is also known as osteonectin or BM-40 (1-5). It is the founding member of a family of secreted matricellular proteins with similar domain structure. The 286 amino acid (aa), 43 kDa protein contains an N-terminal acidic region that binds calcium, a follistatin domain that contains Kazal-like sequences, and a C-terminal extracellular calcium (EC) binding domain with two EF-hand motifs (1-5). Crystal structure modeling shows that residues implicated in cell binding, inhibition of cell spreading, and disassembly of focal adhesions cluster on one face of SPARC, while a collagen binding epitope and an N-glycosylation site are opposite this face (6). SPARC is produced by fibroblasts, capillary endothelial cells, platelets and macrophages, especially in areas of tissue morphogenesis and remodeling (3, 7). SPARC shows context-specific effects, but generally inhibits adhesion, spreading and proliferation, and promotes collagen matrix formation (3-5). For endothelial cells, SPARC disrupts focal adhesions and binds and sequesters PDGF and VEGF (3-5). SPARC is abundantly expressed in bone, where it promotes osteoblast differentiation and inhibits adipogenesis (5, 8). SPARC is potentially cleaved by metalloproteinases, producing an angiogenic peptide that includes the copper-binding sequence KGHK (7). Paradoxically, SPARC is highly expressed in many tumor types undergoing an endothelial to mesenchymal transistion; its expression, however, mainly decreases the likelihood of metastasis and confers sensitivity to chemotherapy and radiation (4, 9-11). Stabilin-1, which is expressed on alternately activated macrophages, is the first SPARC receptor to be identified. It binds the SPARC EC domain and mediates endocytosis for degradation (12). Mature human SPARC shows 92%, 92%, 97%, 99%, 96%, and 85% aa identity with mouse, rat, canine, bovine, porcine, and chick SPARC, respectively.
References
- Lankat-Buttgereit, B. et al. (1988) FEBS Lett. 236:352.
- Sweetwyne, M.T. et al. (2004) J. Histochem. Cytochem. 52:723.
- Sage, H. et al. (1989) J. Cell Biol. 109:341.
- Framson, P.E. and E.H. Sage (2004) J. Cell. Biochem. 92:679.
- Alford, A.I. and K. D. Hankenson (2006) Bone 38:749.
- Hohenester, E et al. (1997) EMBO J. 16:3778.
- Sage, E.H. et al. (2003) J. Biol. Chem. 278:37849.
- Delany, A.M. et al. (2003) Endocrinology 144:2588.
- Robert, G. et al. (2006) Cancer Res. 66:7516.
- Koblinski, J.E. et al. (2005) Cancer Res. 65:7370.
- Tai, I.T. et al. (2005) J. Clin. Invest. 115:1492.
- Kzhyshkowska, J. et al. (2006) J. Immunol. 176:5825.
Long Name
Alternate Names
Gene Symbol
UniProt
Additional SPARC Products
Product Documents for Human SPARC Antibody
Product Specific Notices for Human SPARC Antibody
For research use only